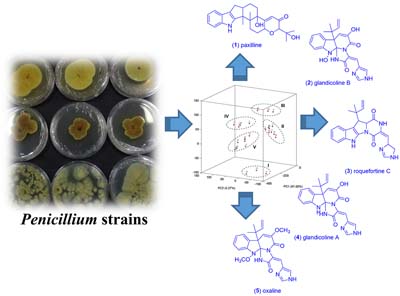

vol. 32, No. 9, 2021, p. 1687-1894
Contamination by pollutants from anthropogenic activities is a serious environmental issue. This illustration represents the biodegradation of fluoranthene, a polycyclic aromatic hydrocarbon, by fungi isolated from the Brazilian tropical peat of Santo Amaro das Brotas (Sergipe state) with the identification of biotransformation products. Showing that these microorganisms present potential for bioremediation. Details are presented in the Article Biodegradation of the Polycyclic Aromatic Hydrocarbon Fluoranthene by Fungi Strains from a Brazilian Tropical Peat by Anuska C. F. S. Garcia, Willian G. Birolli, Bruno R. Araújo, Carla G. Marques, Antônio M. Barbosa-Junior, Leandro E. C. Diniz, André L. M. Porto and Luciane P. C. Romão on page 1874.
Biodegradation of the Polycyclic Aromatic Hydrocarbon Fluoranthene by Fungi Strains from a Brazilian Tropical Peat
Anuska C. F. S. Garcia  ; Willian G. Birolli
; Willian G. Birolli  ; Bruno R. Araújo
; Bruno R. Araújo  ; Carla G. Marques
; Carla G. Marques  ; Antônio M. Barbosa-Junior
; Antônio M. Barbosa-Junior  ; Leandro E. C. Diniz
; Leandro E. C. Diniz  ; André L. M. Porto
; André L. M. Porto  ; Luciane P. C. Romão
; Luciane P. C. Romão

Contamination by pollutants from anthropogenic activities is a serious environmental issue. This illustration represents the biodegradation of fluoranthene, a polycyclic aromatic hydrocarbon, by fungi isolated from the Brazilian tropical peat of Santo Amaro das Brotas (Sergipe state) with the identification of biotransformation products. Showing that these microorganisms present potential for bioremediation. Details are presented in the Article Biodegradation of the Polycyclic Aromatic Hydrocarbon Fluoranthene by Fungi Strains from a Brazilian Tropical Peat by Anuska C. F. S. Garcia, Willian G. Birolli, Bruno R. Araújo, Carla G. Marques, Antônio M. Barbosa-Junior, Leandro E. C. Diniz, André L. M. Porto and Luciane P. C. Romão on page 1874.
https://dx.doi.org/10.21577/0103-5053.20210078
Review J. Braz. Chem. Soc. 2021, 32(9), 1687-1710
Nanobiosensors for Pathogenic Agents Detection
Mayra Beltrán-Pineda; Diana Peña-Solórzano  ; César Augusto Sierra
; César Augusto Sierra

This review provides an overview and update regarding the use of some nanomaterials as biosensors, which have shown attractive results over the last few years.
https://dx.doi.org/10.21577/0103-5053.20210081
J. Braz. Chem. Soc. 2021, 32(9), 1711-1738
Interfacial Electron Transfer in Dye-Sensitized TiO2 Devices for Solar Energy Conversion
Andressa V. Müller  ; Wendel M. Wierzba; Mariana N. Pastorelli; André S. Polo
; Wendel M. Wierzba; Mariana N. Pastorelli; André S. Polo

The interfacial electron transfer reactions that take place in dye-sensitized TiO2 molecular devices for solar energy conversion govern their efficiency. This review visits general aspects of these reactions.
https://dx.doi.org/10.21577/0103-5053.20210083
Articles J. Braz. Chem. Soc. 2021, 32(9), 1739-1751
Use of Aluminosilicate Residue from Insulators of High Voltage Transformers for the Adsorption of Basic Dyes
Fernando C. G. Murga; José D. R. de Campos; Roberta Signini

In this study, an aluminosilicate residue of high voltage transformer insulators was used as an adsorbent in basic dye solutions and its parameters and adsorption properties were investigated during the process.
https://dx.doi.org/10.21577/0103-5053.20210065
J. Braz. Chem. Soc. 2021, 32(9), 1752-1761
Ultrasonic Pretreatment of Cowpea Bean Pod with K3PO4: Effect on Bio-Oil Yield and Phenolic Compounds Content
Diego F. Bispo  ; Roberta M. Santos
; Roberta M. Santos  ; Honnara S. Granja; Lisiane S. Freitas
; Honnara S. Granja; Lisiane S. Freitas

Biomass with K3PO4 subjected to different pretreatments resulted in increased phenolics yields.
https://dx.doi.org/10.21577/0103-5053.20210066
J. Braz. Chem. Soc. 2021, 32(9), 1762-1772
Evaluation of Potentially Toxic Elements in Mundaú Lagoon (Maceió, AL-Brazil): Systematic Environmental Monitoring of Water and Food Quality
Mayara C. dos Santos; Reginaldo C. da Silva Filho; Ana Catarina R. Leite; Clésia C. Nascentes; Wander G. Botero; Josué C. C. Santos

Environmental monitoring of potentially toxic elements in water and Mytella charruana (sururu) from Mundaú lagoon (Maceió, AL, Brazil).
https://dx.doi.org/10.21577/0103-5053.20210067
J. Braz. Chem. Soc. 2021, 32(9), 1773-1779
Simultaneous LC-MS/MS Determination of Sacubitril, Valsartan and LBQ657 in Human Plasma and Its Application to Clinical Study
Yufeng Ni; Yujia Zhang; Chong Zou; Li Ding

Development and validation of a liquid chromatography-tandem mass spectrometry (LC-MS/MS) method for the simultaneous determination of sacubitril, valsartan and LBQ657 (a metabolite of sacubitril) in human plasma and its application to clinical study.
https://dx.doi.org/10.21577/0103-5053.20210068
J. Braz. Chem. Soc. 2021, 32(9), 1780-1788
Design, Synthesis and Structural Confirmation of a Series of 2-(Thiophen-2-yl)- 4H-chromen-3-yl-sulfonate Derivatives and Preliminary Investigation of Their Antioxidant and Anticancer Potentials
Jialin Zang; Ming Bu; Jifang Yang; Lu Han; Zhen Lv

A series of novel 2-(thiophen-2-yl)-4H-chromen-3-yl-sulfonate derivatives (4a-4n) were synthesized and investigated for their in vitro free radical scavenging potential as well as cytotoxic efficacies against selected cancer cell lines.
https://dx.doi.org/10.21577/0103-5053.20210069
J. Braz. Chem. Soc. 2021, 32(9), 1789-1801
Optimized Synthesis of Molecularly Imprinted Hybrid Polymer by Factorial Design for Selective Caffeine Extraction in Surface Water
Fabiana Casarin; Camila S. Dourado; Luana S. Sousa; Marco T. Grassi  ; Ana C. B. Dias
; Ana C. B. Dias

A hybrid molecular imprinted polymer was optimized by factorial design to obtain the best conditions for caffeine extraction in surface water. Caffeine is an important emerging contaminant used as anthropogenic marker to indicate the presence of water supplies contamination.
https://dx.doi.org/10.21577/0103-5053.20210070
J. Braz. Chem. Soc. 2021, 32(9), 1802-1812
Synthesis, Structure Determination and Catalytic Activity of a Novel Ruthenium(II) [RuCl(dppb)(44bipy)(4-pic)]PF6 Complex
Rafael G. da Silveira  ; Angel R. Higuera-Padilla; Beatriz N. da Cunha; João H. de Araujo Neto
; Angel R. Higuera-Padilla; Beatriz N. da Cunha; João H. de Araujo Neto  ; Anderson J. L. Catão; Luiz A. Colnago; Eduardo E. Castellano; Alzir A. Batista
; Anderson J. L. Catão; Luiz A. Colnago; Eduardo E. Castellano; Alzir A. Batista

This research in coordination chemistry reports the synthesis and characterization of a new RuII complex, together with the evaluation of its catalytic activity for hydrogenation of ketones in real time by 1H nuclear magnetic resonance (NMR).
https://dx.doi.org/10.21577/0103-5053.20210071
Total access: 2035
J. Braz. Chem. Soc. 2021, 32(9), 1813-1821
In vitro Photoprotective Evaluation and Development of Novel Nanoemulsion with Chromone Derivative
Amanda S. Antunes; Ana Paula Gouveia; Gabriela M. Diogo; Jason G. Taylor; Lucas R. D. Sousa; Tatiane R. Amparo; Fernanda B. Perasoli; Orlando D. H. dos Santos; Thiago Cazati  ; Paula M. A. Vieira; Ricardo G. Penido; Viviane M. R. dos Santos
; Paula M. A. Vieira; Ricardo G. Penido; Viviane M. R. dos Santos

Chromone derivatives were synthetized and their photoprotective properties were evaluated.
https://dx.doi.org/10.21577/0103-5053.20210072
J. Braz. Chem. Soc. 2021, 32(9), 1822-1831
Hierarchization of Zeolites A and X Using Bacterial Cellulose as Macroporous Support
Raquel A. Bessa; André Luís S. Pereira; Morsyleide F. Rosa; Michael W. Anderson; Adonay R. Loiola

Cartridges with oxidized and non-oxidized cellulose were studied with different zeolites to assess some properties of such hierarchical materials.
https://dx.doi.org/10.21577/0103-5053.20210073
J. Braz. Chem. Soc. 2021, 32(9), 1832-1839
Screening of Alkaloid-Producing Endophytic Penicillium Strains from Amazon Medicinal Plants by Electrospray Ionization Mass Spectrometry (ESI-MS) and Principal Component Analysis (PCA)
Francinaldo A. da Silva-Filho; Marjory M. M. de Souza; Gabriel O. Rezende; Felipe M. A. da Silva  ; Jeferson C. da Cruz
; Jeferson C. da Cruz  ; Gilvan F. da Silva
; Gilvan F. da Silva  ; Afonso D. L. de Souza
; Afonso D. L. de Souza  ; Antonia Q. L. de Souza
; Antonia Q. L. de Souza
The electrospray ionization mass spectrometry (ESI-MS) and principal component analysis (PCA) provided a simple and effective approach to screening alkaloid-producing endophytic Penicillium strains from Amazon medicinal plants.
https://dx.doi.org/10.21577/0103-5053.20210074
J. Braz. Chem. Soc. 2021, 32(9), 1840-1850
Evaluation of the Effect of Brazilian Savanna (Cerrado) Seasons in Flavonoids and Alkaloids Accumulation: The Case of Duguetia furfuracea
Arthur L. Macedo; Amanda G. Boaretto; André N. da Silva; Débora S. Maia; João M. de Siqueira; Denise B. Silva; Carlos A. Carollo

Alkaloids are virtually perennial, with qualitative variation during the year, and flavonoids accumulate during the rainy season.
https://dx.doi.org/10.21577/0103-5053.20210075
J. Braz. Chem. Soc. 2021, 32(9), 1851-1864
The Role of PEG 6000 and PVP as Stabilizing and Surfactant Agents in the Photoelectrochemical Properties of BiVO4 Monoclinic Structure
Marcelo R. S. Pelissari; Luis Vicente A. Scalvi; Luiz Henrique Dall'Antonia

The remarkable current density of BiVO4 electrode, associated with its morphological and structural properties of the electrode surface.
https://dx.doi.org/10.21577/0103-5053.20210076
J. Braz. Chem. Soc. 2021, 32(9), 1865-1873
Degradation of Reactive Dyes by Thermally Activated Persulfate and Reuse of Treated Textile Dye-Bath
Amanda O. Basilio  ; Lucas Dohler; Matheus Servin; Carlos A. K. Gouvea; Ronny R. Ribeiro; Patricio Peralta-Zamora
; Lucas Dohler; Matheus Servin; Carlos A. K. Gouvea; Ronny R. Ribeiro; Patricio Peralta-Zamora

Advanced oxidation processes with persulfate enable the treatment of textile dye wastewater, which allows its reuse.
https://dx.doi.org/10.21577/0103-5053.20210077
J. Braz. Chem. Soc. 2021, 32(9), 1874-1883
Biodegradation of the Polycyclic Aromatic Hydrocarbon Fluoranthene by Fungi Strains from a Brazilian Tropical Peat
Anuska C. F. S. Garcia  ; Willian G. Birolli
; Willian G. Birolli  ; Bruno R. Araújo
; Bruno R. Araújo  ; Carla G. Marques
; Carla G. Marques  ; Antônio M. Barbosa-Junior
; Antônio M. Barbosa-Junior  ; Leandro E. C. Diniz
; Leandro E. C. Diniz  ; André L. M. Porto
; André L. M. Porto  ; Luciane P. C. Romão
; Luciane P. C. Romão

The biodegradation of the polycyclic aromatic hydrocarbon (PAH) fluoranthene by fungi from a Brazilian tropical peat was reported with the identification of metabolites.
https://dx.doi.org/10.21577/0103-5053.20210078
J. Braz. Chem. Soc. 2021, 32(9), 1884-1894
Whey Isolation from Rejected Human Milk and Its Lipid Content Characterization by GC-FID and ESI-MS
Eloize S. Alves; Matheus C. Castro  ; Bruno H. F. Saqueti; Luciana P. Manin
; Bruno H. F. Saqueti; Luciana P. Manin  ; Roberta da Silveira
; Roberta da Silveira  ; Patrícia M. Souza; Oscar O. Santos
; Patrícia M. Souza; Oscar O. Santos  ; Jesuí V. Visentainer
; Jesuí V. Visentainer

Human whey obtained by ultracentrifugation, and its characterization regarding triacylglycerol profile and proximate and fatty acid composition.
https://dx.doi.org/10.21577/0103-5053.20210092
Online version ISSN 1678-4790 Printed version ISSN 0103-5053
Journal of the Brazilian Chemical Society
JBCS Editorial and Publishing Office
University of Campinas - UNICAMP
13083-970 Campinas-SP, Brazil
Free access










